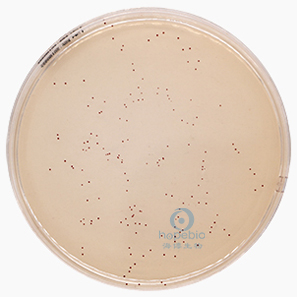
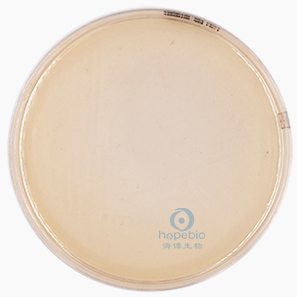

用途:用于羽绒羽毛制品中肠球菌检测。
用法:
Suspend 42.0 g in 1 litre of distilled water and bring to the boil to dissolve the agar completely,Cool to 50-55°C,dispense into Petri dishes .
称取本品42.0g,加热溶解于 1000ml 蒸馏水中,冷至 50-55℃左右时,倾入无菌平皿,备用。
检验原理:
蛋白胨提供碳源和氮源;葡萄糖提供能源;磷酸二氢钠为缓冲剂;酵母膏粉提供B 族维生素、氨基酸;琼脂是培养基的凝固剂;叠氮化钠为选择性抑菌剂可抑制细菌的生长;TTC 为色素。
不同细菌在SLANETZ和BARTLEY培养基上的生长特征:

|
|
|
|
|
|
肠球菌
红色菌落
|
|
|
|
粪肠球菌
红色菌落
|
|
|
|
|
|
|
|
|
|

|
|
金黄色葡萄球菌
抑制
|
|
|
|
大肠埃希氏菌
抑制
|
SLANETZ和BARTLEY培养基微生物灵敏度试验:
按标签用法制备培养基,接种以下质控菌株,放置30±2℃需氧培养24-48小时。
注:回收率计算时,用TSA琼脂做对照培养基。
相关资料:
操作视频|培养基的加热灭菌操作(以XLD 、SC为例)-点击查看实验操作视频
Slanetz和Bartley培养基原理及现象 点击查看